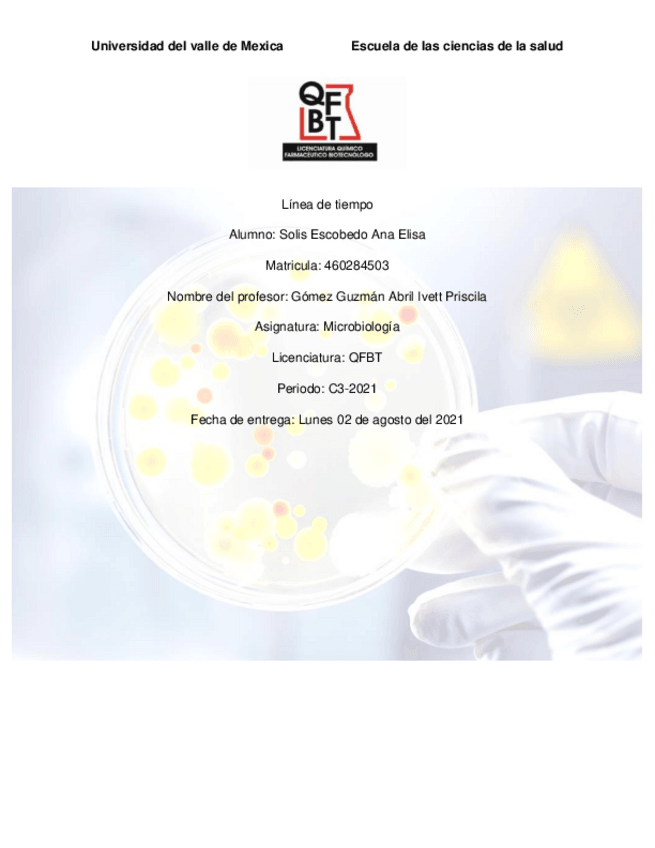

Químico Farmacéutico Biotecnólogo (UVM)
Zapopan
Sube tus apuntes
arrow_forwardAsignaturas de Químico Farmacéutico Biotecnólogo (UVM)
Asignatura
arrow_downward8º
•
0 posts
2º
•
2 posts
4º
•
3 posts
8º
•
0 posts
1º
•
9 posts
4º
•
0 posts
7º
•
0 posts
2º
•
1 posts
3º
•
0 posts
5º
•
0 posts
7º
•
0 posts
2º
•
0 posts
1º
•
1 posts
8º
•
0 posts
8º
•
0 posts
6º
•
0 posts
8º
•
0 posts
4º
•
11 posts
9º
•
0 posts
7º
•
0 posts
6º
•
1 posts
5º
•
0 posts
1º
•
12 posts
2º
•
2 posts
5º
•
0 posts
5º
•
0 posts
1º
•
0 posts
1º
•
0 posts
6º
•
0 posts
8º
•
0 posts
9º
•
0 posts
3º
•
5 posts
4º
•
0 posts
5º
•
3 posts
1º
•
0 posts
3º
•
0 posts
4º
•
0 posts
5º
•
0 posts
9º
•
0 posts
1º
•
20 posts
2º
•
0 posts
2º
•
0 posts
3º
•
0 posts
4º
•
0 posts
6º
•
0 posts
6º
•
0 posts
7º
•
0 posts
3º
•
9 posts
9º
•
0 posts
7º
•
0 posts
Últimas publicaciones de Químico Farmacéutico Biotecnólogo (UVM)
Cuadro sinoptico de la farmacología aplicada al sistema sistema nervioso autónomo.
He publicado nuevos trabajos de 2º Bioquímica I: Mapa-mental-Metabolismo.pdf
He publicado nuevos trabajos de 1º Comunicación y Negociación: Triptico-Reglamento-UVM.pdf
He publicado nuevos apuntes de 1º Biología Celular: Triptico-divison-celular.pdf
He publicado nuevos apuntes de 1º Biología Celular: Caracteristicas-fisicoquimicas-de-los-lipidos.pdf
He publicado nuevos apuntes de 1º Química General: adaptacion-celular.pdf
He publicado nuevos apuntes de 4º Equilibrio Heterogéneo: Citar-en-APA-gmmp.pdf
He publicado nuevos apuntes de 1º Biología Celular: Seguridad-del-lab.docx
He publicado nuevos apuntes de 1º Química General: FORMULARIO-Calculo-de-moles.pdf
He publicado nuevos apuntes de 9º Desarrollo Emprendedor en Ciencias de la Salud: 16-tabla-de-parametros-farmacocineticos.pdf
He publicado nuevos apuntes de 3º Termodinámica: 14-Antes-de-Practica-.pdf
He publicado nuevos apuntes de 3º Termodinámica: 13-ENERGIA-LIBRE-DE-GIBBS.pdf
He publicado nuevos apuntes de 3º Termodinámica: 10-PROPIEDADES-COLIGATIVAS.pdf
He publicado nuevos apuntes de 3º Termodinámica: SEGUNDA-Y-TERCERA-LEY-DE-LA-TERMODINAMICA.pdf
He publicado nuevos apuntes de 3º Termodinámica: Primera-ley-de-la-termodinamica.pdf
He publicado nuevos apuntes de 3º Termodinámica: Tipos-de-calorimetros.pdf
He publicado nuevos apuntes de 3º Termodinámica: Generidades-de-los-gases-.pdf
He publicado nuevos apuntes de 1º Física I: Analisis-dimensional-.pdf
He publicado nuevos apuntes de 4º Equilibrio Heterogéneo: Generalidades-de-Embriologia-completo.pdf
He publicado nuevos apuntes de 4º Equilibrio Heterogéneo: Grupos-muscularesBRAZO.pdf
He publicado nuevos apuntes de 4º Equilibrio Heterogéneo: Organizacion-del-sistema-nervioso.pdf
He publicado nuevos apuntes de 4º Equilibrio Heterogéneo: Sistema-circulatorio.pdf
He publicado nuevos apuntes de 4º Equilibrio Heterogéneo: Sistema-Digestivo-completo.pdf
He publicado nuevos apuntes de 4º Equilibrio Heterogéneo: Sistema-locomotor-1.pdf
He publicado nuevos apuntes de 4º Equilibrio Heterogéneo: Sistema-Respiratorio.pdf
He publicado nuevos apuntes de 4º Equilibrio Heterogéneo: Sistema-urinario.pdf
He publicado nuevos apuntes de 4º Equilibrio Heterogéneo: Tejido-oseo-y-planimetria.pdf
He publicado nuevos apuntes de 1º Química General: Clasificacion-cuantica-de-los-elementos-.pptx
He publicado nuevos apuntes de 1º Química General: Soluciones-molares-y-normales-.pptx
practicas
-
química general
He publicado nuevos practicas de 1º Química General: química general
practicas
-
química general
He publicado nuevos practicas de 1º Química General: química general
He publicado nuevos apuntes de 1º Química General: Fuerza-de-los-acidos-y-bases.pdf
He publicado nuevos apuntes de 1º Química General: Preparacion-de-Sol.pdf
He publicado nuevos apuntes de 1º Química General: Formas-de-expresar-una-solu.pdf
He publicado nuevos apuntes de 1º Química General: Ensayo-a-la-flama.pdf
He publicado nuevos apuntes de 3º Microbiología I: Actividad-1-Linea-del-tiempo.pdf